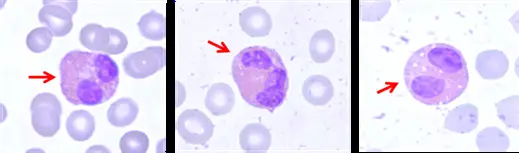
圖片

109年:(醫檢)血液(2)
箭頭所指的細胞最有可能是下列何者?
AEosinophil
BLarge granular lymphocyte
CMast cell
DDendritic cell
詳細解析
本題觀念:
本題考核周邊血液抹片(peripheral blood smear)的白血球形態辨識,重點在區分嗜酸性球(eosinophil)、大顆粒淋巴球(large granular lymphocyte, LGL)、肥大細胞(mast cell)與樹突細胞(dendritic cell)的顯微鏡下特徵。
影像分析:
圖中呈現三個血液抹片視野,每個視野以紅色箭頭指向一個目標細胞,背景可見大量正常紅血球(粉紅色圓形無核細胞)。
箭頭所指的細胞具有以下形態特徵:
- 細胞大小:明顯大於周圍紅血球,直徑約 12–17 µm
- 細胞核:呈雙葉狀(bilobed),兩葉輪廓光滑,以細薄染色質絲相連,染色呈深紫色
- 細胞質顆粒:充滿大量粗大、均勻的圓形顆粒,在 Wright-Giemsa 染色下顯現出特徵性的橘紅色(eosinophilic),幾乎填滿整個細胞質
上述特徵——雙葉核 + 大量粗大橘紅色顆粒——是嗜酸性球(eosinophil)的診斷性形態特徵,在三個視野中均可清晰辨識。
選項分析
(A) Eosinophil(嗜酸性球) 形態特徵完全符合:雙葉核(bilobed nucleus)、細胞質充滿大量粗大的嗜伊紅性(eosinophilic)顆粒,顆粒含鹼性蛋白(major basic protein, MBP)
...(解析預覽)...

升級 VIP 解鎖圖文解析